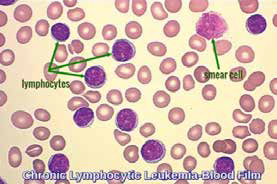
389-390期《全球肿瘤快讯》-80.jpg

- 院所概况
- 就诊服务
-
科室介绍
科室介绍
特色医疗
特色科室
- 胃肠肿瘤中心一病区
- 胃肠肿瘤中心二病区
- 胃肠肿瘤中心三病区
- 胃肠肿瘤中心四病区
- 肝胆胰外一科
- 胸外一科
- 肝胆胰外二科
- 胸外二科
- 乳腺癌预防治疗中心
- 妇科肿瘤科
- 头颈外科
- 骨与软组织肿瘤科
- 泌尿外科
- 家族遗传性肿瘤中心
- 乳腺肿瘤内科
- 胸部肿瘤内一科
- 胸部肿瘤内二科
- 淋巴肿瘤内科
- 消化肿瘤内科
- 黑色素瘤与肉瘤内科
- 泌尿肿瘤内科
- 日间化疗病区
- 中西医结合科暨老年肿瘤科
- 康复科
- 介入治疗科
- 口腔科
- 肿瘤放疗科
- 手术室
- 重症医学科
- 麻醉科
- I期临床病区
- VIP-II
- VIP-Ⅰ
- 移植与免疫治疗病区
- 疼痛门诊
- 肿瘤外科
- 肿瘤内科
- 心内科1
- 肿瘤中医
- 疼痛与睡眠
- 康复中医
- 综合研究型病房
- 职工保健
- 支持治疗科
- 生化与分子生物学研究室
- 病因学研究室
- 遗传学研究室
- 流行病学研究室
- 分子肿瘤学研究室
- 中心实验室
- 临床实验室
- 图书馆
- 实验动物室
- 生物样本库
- 细胞生物学研究室
- 家族遗传性肿瘤中心实验室
- 肿瘤生物信息中心
- 胃肠肿瘤生物学研究室
临床科室医技科室基础科室行政处室 -
专家介绍
专家介绍
-
科普园地
科普园地
疾病专题
健康大讲堂
-
仁医陈敏华 用射频针创造生命艺术 浏览量:3718
-
【北京您早】恶性肿瘤成北京市民头号杀手 浏览量:1683
-
【生活大调查】终结癌症传言 浏览量:2730
科普园地
防治雾霾
健康自测
-
食管癌切除术后生存预测
| 北京市重点肿瘤高危人群自我评…
| 疲劳度自测
| 便秘自测
| 自己检查胃肠病
癌症康复杂志
《癌症康复》分为三大部分。第一部分癌症康复总论,主要介绍了癌症病人的心理调整、饮食营养、心身锻炼、生活指导等基本的康复知识、技能和方法。
综合资讯
-
- 招聘动态
-
院务公开
院务公开
-
院刊杂志
院刊杂志
Chinese Journal of Cancer Research
The Chinese Journal of Cancer Research publishes high-quality original articles reporting new information on basic and clinical aspects of cancer research and related subjects.
全球肿瘤快讯
院报专栏
癌症康复杂志
《癌症康复》分为三大部分。第一部分癌症康复总论,主要介绍了癌症病人的心理调整、饮食营养、心身锻炼、生活指导等基本的康复知识、技能和方法。